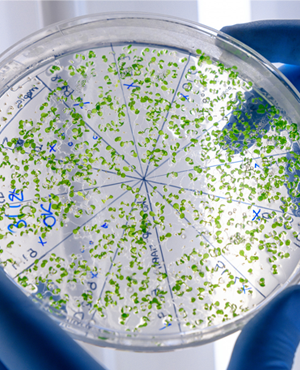

Productos
Ablandador de Agua
Se utiliza un sistema de ablandamiento para disminuir la dureza del agua entregando una calidad de <5 ppm CaCO3 de dureza total. El sistema consiste en una columna de fibra de vidrio con válvula de accionamiento hidráulico y controlador digital, el cual permite que el ablandador realice las secuencias de lavado y regeneración en forma automática al horario programado.
Tabletas Cloradas
Las tabletas de cloración están diseñadas para asegurar una eficiente desinfección de los efluentes de plantas de aguas servidas y RILES de todas las marcas y modelos nacionales o importadas, que presenten una alta carga bacteriana.
Las tabletas se disuelven en forma lenta liberando cloro activo, en forma económica debido a su alta concentración y su efecto desinfectante. Las tabletas de hipoclorito de calcio, son las indicadas como elemento de desinfección, permitiendo obtener efluentes, con concentraciones de Coliformes fecales, bajo las 1000 NMP/100 ml, indicado en la legislación nacional vigente (D.S. 90/2000 y D.S. 46/2002).

Tabletas Decloradas
Las tabletas compactas de decloración están diseñadas para asegurar una eficiente eliminación
del cloro residual de los efluentes de plantas de aguas servidas y RILES de todas las marcas y
modelos nacionales o importadas, evitando la formación de compuestos organoclorados. Las
tabletas, se disuelven en forma lenta liberando sulfito de sodio, en forma económica debido a su
alta concentración y su efecto neutralizante del cloro libre.
Las tabletas
Bacterías Benéficas
En un producto 100% Natural, inofensivo para el hombre y medio ambiente, compuesto de bacterias benéficas adaptadas para vivir en ambientes hostiles como son grasas, fecas animales y humanas, así como en desechos orgánicos de la agroindustria
Principales usos:
- Fosas Sépticas
- Cámara desengrasadoras
- Tratamientos de laguna de oxidación
- Control de olores y reducción de amoníaco en granjas de producciones animales y avícolas.
- Pantas de tratamiento de aguas servidas disuelve la materia orgánica, transformándola en agua y en dióxido de carbono
- Elimina el mal olor de todo tipo de desechos orgánicos.
- Control de olores y reducción de amoníaco en granjas de producciones animales y avícolas.